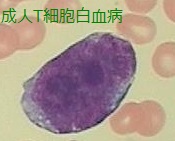
これも成人T細胞白血病(ATL)細胞 これも成人T細胞白血病(ATL)細胞

成人T細胞白血病・成人T細胞リンパ腫(ATLL)[日本甲状腺学会認定 甲状腺専門医 橋本病 バセドウ病 甲状腺超音波エコー 長崎甲状腺クリニック 大阪]
甲状腺:専門の検査/治療/知見③ 橋本病 バセドウ病 甲状腺エコー 長崎甲状腺クリニック大阪
甲状腺専門の長崎甲状腺クリニック(大阪府大阪市東住吉区)院長が海外・国内論文に眼を通して得た知見、院長自身が大阪市立大学(現、大阪公立大学) 代謝内分泌内科学講座で得た知識・経験・行った研究、甲状腺学会で入手した知見です。
長崎甲状腺クリニック(大阪)以外の写真・図表はPubMed等で学術目的にて使用可能なもの(Creative Commons License)、public health目的で官公庁・非営利団体等が公表したものを一部改変しています。引用元に感謝いたします。尚、本ページは長崎甲状腺クリニック(大阪)の経費で非営利的に運営されており、広告収入は一切得ておりません。
甲状腺・動脈硬化・内分泌代謝・糖尿病に御用の方は 甲状腺編 動脈硬化編 甲状腺以外のホルモンの病気(副甲状腺/副腎/下垂体/妊娠・不妊など) 糖尿病編 をクリックください。
写真は、成人T細胞白血病細胞、核の形から花細胞(flower cell)と呼ばれます。
長崎甲状腺クリニック(大阪)は甲状腺専門クリニックです。成人T細胞白血病の診療を行っておりません。
Summary
HTLV-1(成人T細胞白血病ウイルス1)キャリアーの約40%は都心に集中。橋本病ではHTLV-Iキャリアー率が高い。甲状腺機能亢進症によりHTLV-1感染細胞が増える。バセドウ病にHTLV-1関連ぶどう膜炎を合併すると、高熱・眼痛・視力低下にてバセドウ病眼症・原田病・サルコイドーシス・ベーチェット病との鑑別必要。メルカゾール投与でHTLV-1関連ぶどう膜炎をおこし、中止すると沈静化。橋本病で発生しやすい甲状腺悪性リンパ腫の腫瘍マーカーsIL2-R(可溶性インターロイキン2受容体)は成人T細胞白血病・成人T細胞リンパ腫(ATLL)でも上昇。
Keywords
HTLV-1,成人T細胞白血病ウイルス,キャリアー,橋本病,甲状腺機能亢進症,バセドウ病,HTLV-1関連ぶどう膜炎,成人T細胞リンパ腫,成人T細胞白血病,ATLL
日本においてHTLV-1(成人T細胞白血病ウイルス1型)に感染している人は人口の約1%と推定されます。HTLV-1(成人T細胞白血病ウイルス1型)キャリアーの約40%は、近畿、中部、関東に集中しており、もはや九州・沖縄・四国だけの問題ではありません。大都市圏に人が移動するためと考えられます。
HTLV-1(成人T細胞白血病ウイルス1型)キャリアーの約5% が、成人T細胞白血病・成人T細胞リンパ腫(ATLL)を発症します。発症平均年齢は55 歳です。
HTLV-1(成人T細胞白血病ウイルス1型)の主な感染経路は母乳を介した母児感染(垂直感染)です。妊娠時スクリーニング検査の普及により、母親がキャリアと分かれば、人工乳への切り替えにより母児感染は防げます。
さらに、献血時の抗HTLV-I抗体検査で妊娠前にHTLV-1(成人T細胞白血病ウイルス1型)キャリアーと分かる機会も増えています。
HTLV-1感染で
- 末梢血の異常リンパ球が5%以下の場合、成人T細胞白血病・成人T細胞リンパ腫(ATLL)診断には組織学的に証明された腫瘍部位を必要とする
- くすぶり型(末梢血の異常Tリンパ球 ≧5%だが)または 予後不良因子のない慢性型成人T細胞白血病 は急性転化するまで経過観察
- 予後不良因子を1つでも有する慢性型成人T細胞白血病は、積極的な治療適応
予後不良因子① LD>基準値上限、② BUN>基準値上限、③ 血清アルブミン(ALB)<基準値下限
成人T細胞白血病・成人T細胞リンパ腫(ATLL)の症状は
- 痒みを伴う紅斑が出現[成人T細胞白血病(ATL)細胞の皮膚浸潤による]→皮膚科を受診し、抗アレルギー薬と副腎皮質ステロイド外用薬で治療しても改善せず、紅斑が広がる
- 全身のリンパ節腫大(頸部、腋窩、鼠径部など)
- 高熱
- 高カルシウム血症[腫瘍随伴体液性高カルシウム(Ca)血症(humoral hypercalcemia of malignancy: HHM)]
成人T細胞白血病・成人T細胞リンパ腫(ATLL)の検査所見・診断は
- 血液検査でHTLV-1抗体(PA)が陽性だった場合;ゼラチン粒子凝集(PA)法はスクリーニング検査につき、擬陽性の可能性があるため精密測定(ウエスタンブロット法)が勧められます
- 白血球数高値(異常リンパ球増加→花弁細胞(フラワー細胞)
- 代謝亢進による高LD血症、高尿酸血症
- 高カルシウム血症、腎障害
- sIL2-R(可溶性インターロイキン2受容体)高値
- フローサイトメトリー検査;CD3、CD4、CD25陽性
アグレッシブ成人T細胞白血病・成人T細胞リンパ腫(ATLL)の治療は、
- 多剤併用抗腫瘍化学療法;8種類の抗がん剤を組み合わせたVCAP-AMP-VECP療法
VCAP〈ビンクリスチン,シクロホスファミド,ドキソルビシン,プレドニゾロン〉
AMP〈ドキソルビシン,ラニムスチン,プレドニゾロン〉
VECP〈ビンデシン,エトポシド,カルボプラチン,プレドニゾロン〉 - 同種造血幹細胞移植
- 高カルシウム血症の治療
バセドウ病の経過中に成人T細胞白血病(ATL)やHTLV-1[human T-cell leukemia virus type 1 (HTLV-1) 、ヒトT細胞白血病ウイルス1型]関連ぶどう膜炎(HAU)を合併した症例では、
- B細胞主体の通常バセドウ病と異なり、甲状腺の浸潤リンパ球集簇部ではT・B細胞比率が同じ、濾胞間や上皮間ではCD4陽性T細胞が混在するも、B細胞はほとんどみられない(5回日本臨床電顕学会抄録集,1993,p.Sl53)。
- 甲状腺機能亢進症による代謝亢進で、HTLV-1感染細胞が増える(Jpn J Cancer Res. 1998 Jun;89(6):608-14.)
特に、バセドウ病にHTLV-1関連ぶどう膜炎(HAU:HTLV-1-associated uveitis)を合併した症例では、高熱・眼痛・視力低下を起こします。
- 甲状腺眼症(バセドウ病眼症) ・原田病(フォークト―小柳―原田病)・サルコイドーシス・ベーチェット(Behçet)病との鑑別必要
- 抗甲状腺薬(メルカゾール)との関連が示唆されていて、HTLV-1キャリアーのバセドウ病患者にメルカゾールを投与し続けるとHTLV-1関連ぶどう膜炎(HAU)を発症します。
PTU(プロパジール/チウラジール)に変更すると、HTLV-1関連ぶどう膜炎(HAU)は自然に沈静化します(筆者も自験例で確認しました)。
過去の報告では、メルカゾール再投与でHTLV-1関連ぶどう膜炎(HAU)も再燃したとされます。(J Clin Endocrinol Metab. 1995 Jun;80(6):1904-7.)(第55回 日本甲状腺学会 P1-01-12 チアマゾール使用中にぶどう膜炎を来したHTLV-1陽性バセドウ病の一例)
- バセドウ病眼症とHTLV-1関連ぶどう膜炎(HAU)の合併もあります。どちらもステロイド治療で軽快します。バセドウ病に発症したHTLV-1関連ぶどう膜炎(HAU)の7.4%に、甲状腺眼症/バセドウ病眼症を合併します。(Am J Med Sci. 2002 Aug;324(2):109-14.)
原発性T細胞リンパ腫は、成人T細胞リンパ腫の流行地域でもまれです。
甲状腺原発成人T細胞白血病リンパ腫(甲状腺原発ATLリンパ腫)の報告があります。偶然か、必然か橋本病(慢性甲状腺炎)が母体にあるため、組織診でB細胞系の非ホジキンリンパ腫、濾胞性リンパ腫(FL)が疑われるも、Tリンパ球がびまん性に浸潤していた。そもそも甲状腺悪性リンパ腫はMALTリンパ腫、びまん性大細胞型Bリンパ腫(DLBCL)、 両者混合型が一般的で、それ以外の型は極めて稀です(甲状腺悪性リンパ腫の種類 )。
B細胞系の非ホジキンリンパ腫に有効なR-CHOP療法は、一時的に少し効果があったが、すぐに無効となる。 再発難治性成人T細胞白血病(ATL)治療薬のレブラミド®(レナリドミド:Lenalidomide)を使用したそうです。(第62回 日本甲状腺学会 P6-3巨大甲状腺腫を認めたHTLV-I抗体陽性甲状腺悪性リンパ腫の一例)
その他、
- 甲状腺乳頭癌と成人T細胞リンパ腫/白血病の合併例[Indian J Pathol Microbiol. 2010 Jan-Mar;53(1):125-7.]
- 橋本病(慢性甲状腺炎)と抗リン脂質抗体症候群を合併した成人T細胞リンパ腫/白血病[Nihon Naika Gakkai Zasshi. 2014 Aug 10;103(8):1935-8.]
- 円形脱毛症、橋本病(慢性甲状腺炎)、尋常性白斑を合併した成人T細胞リンパ腫/白血病を持つ日本人患者[J Dermatol. 2017 Apr;44(4):e79-e80.]
の報告もあります。
成人T細胞白血病(ATL)の約1/3は甲状腺癌はじめ、他臓器癌の合併があるとされます。そもそもTリンパ球は癌細胞に対する防御免疫を司るため、Tリンパ球自体が癌化すれば、正常な免疫防御機構が破綻し、癌の発生を食い止めれなくなります。(Hematol Oncol. 1993 May-Jun;11(3):127-37.)
再発・難治性の成人T細胞白血病に
- CCR4陽性なら分子標的薬モガムリズマブ
- レブラミド®(レナリドミド:Lenalidomide);副作用として5-10%に甲状腺機能低下症
の適応があります
HTLV-1関連関節症(HAAP) を御覧ください。
沖縄県と南西諸島は、HTLV-1(成人T細胞性白血病ウイルス)の浸淫地で、糞線虫との重複感染が多く、糞線虫の感染が成人T細胞白血病(ATL)発症と強く関わると考えられています(Oncogene, 19, 4954 (2000).)。琉球大学の報告では、抗HTLV1抗体が陽性の患者では17.5%に、陰性者では6.7%に 糞線虫感染が認められたそうです(化学と生物 2001: 39(8) 513-517)。
甲状腺関連の上記以外の検査・治療 長崎甲状腺クリニック(大阪)
- 甲状腺編
- 甲状腺編 part2
- 内分泌代謝(副甲状腺/副腎/下垂体/妊娠・不妊等
も御覧ください
長崎甲状腺クリニック(大阪)とは
長崎甲状腺クリニック(大阪)は日本甲状腺学会認定 甲状腺専門医[橋本病,バセドウ病,甲状腺超音波(エコー)検査など]による甲状腺専門クリニック。大阪府大阪市東住吉区にあります。平野区,住吉区,阿倍野区,住之江区,松原市,堺市,羽曳野市,八尾市,東大阪市,天王寺区,生野区,浪速区も近く。